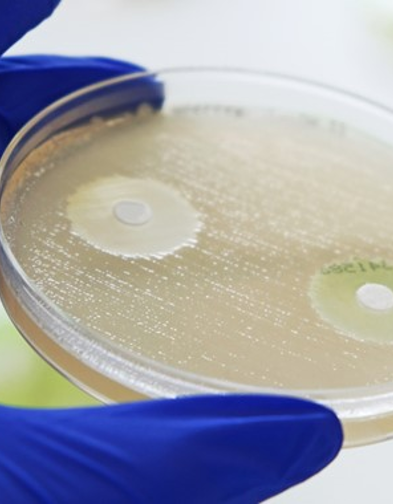
Test Discs
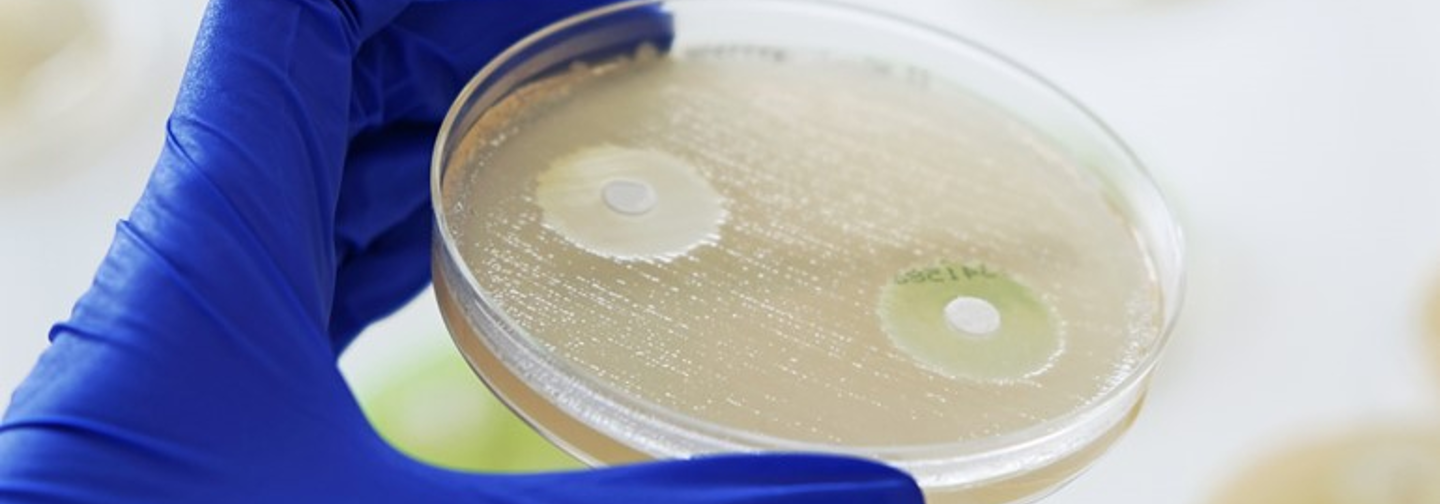
Test Discs
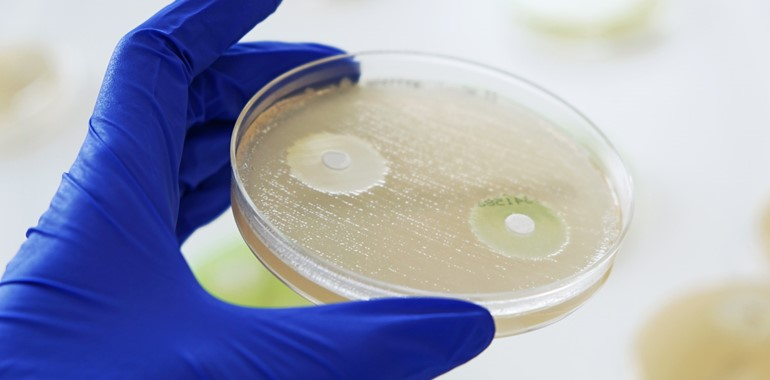

Test Discs
Antibiotic Test Discs for Reliable Susceptibility Testing.
Our high-quality antibiotic test discs are designed for precise and consistent antimicrobial susceptibility testing (AST) in clinical microbiology laboratories.
Each disc is carefully manufactured to ensure accurate diffusion and reliable zone measurements, helping you determine bacterial resistance patterns with confidence. With a wide range of antibiotics available, our test discs support effective diagnostics, optimized treatment decisions, and compliance with international standards.
Popular Products

More InfoASTAMPICILLIN 10ug Cartridge discsIndividual antimicrobial susceptibility test discs in plastic dispensing cartridges containing Ampicillin 10ug
More InfoASTAmoxicillin 3.2mg ADATAB®Freeze dried supplement containing Amoxicillin 3.2mg for agar dilution susceptibility testing.
More InfoASTAMOXICILLIN 25ug Cartridge discsIndividual antimicrobial susceptibility test discs in plastic dispensing cartridges containing Amoxicillin 25ug
More InfoASTMAST® DISCMASTER 6-Place DispenserThe MAST® DISCMASTER 6-Place Dispenser is a reliable and robust hand operated device for the dispensing of AST, ID and combination discs within the MASTDISCS® range.
Video & Text Block
Lorem ipsum dolor sit amet, consectetur adipiscing elit, sed do eiusmod tempor incididunt ut labore et dolore magna aliqua. Ut enim ad minim veniam, quis nostrud exercitation ullamco laboris nisi ut aliquip ex ea commodo consequat. Duis aute irure dolor in reprehenderit in voluptate velit esse cillum dolore eu fugiat nulla pariatur. Excepteur sint occaecat cupidatat non proident, sunt in culpa qui officia deserunt mollit anim id est laborum.
Full width video and optional caption lorem ipsum dolor sit amet, consectetur adipiscing elit, sed do eiusmod tempor incididunt ut labore et dolore magna.

Image & Text Block
Lorem ipsum dolor sit amet, consectetur adipiscing elit, sed do eiusmod tempor incididunt ut labore et dolore magna aliqua. Ut enim ad minim veniam, quis nostrud exercitation ullamco laboris nisi ut aliquip ex ea commodo consequat. Duis aute irure dolor in reprehenderit in voluptate velit esse cillum dolore eu fugiat nulla pariatur. Excepteur sint occaecat cupidatat non proident, sunt in culpa qui officia deserunt mollit anim id est laborum.


Full width image and optional caption lorem ipsum dolor sit amet, consectetur adipiscing elit, sed do eiusmod tempor incididunt ut labore et dolore magna.
Additional Info
Lorem ipsum dolor sit amet, consectetur adipiscing elit, sed do eiusmod tempor incididunt ut labore et dolore magna aliqua. Ut enim ad minim veniam, quis nostrud exercitation ullamco laboris nisi ut aliquip ex ea commodo consequat. Duis aute irure dolor in reprehenderit in voluptate velit esse cillum dolore eu fugiat nulla pariatur. Excepteur sint occaecat cupidatat non proident, sunt in culpa qui officia deserunt mollit anim id est laborum.
Lorem ipsum dolor sit amet, consectetur adipiscing elit, sed do eiusmod tempor incididunt ut labore et dolore magna aliqua. Ut enim ad minim veniam, quis nostrud exercitation ullamco laboris nisi ut aliquip ex ea commodo consequar.”